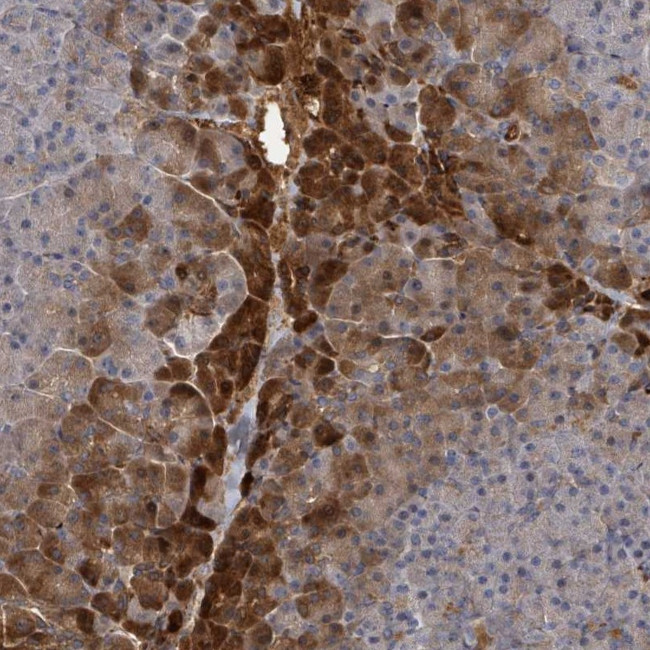
TRPC4AP Antibody in Immunohistochemistry (Paraffin) (IHC (P))

Search
Invitrogen
TRPC4AP Polyclonal Antibody
{{$productOrderCtrl.translations['antibody.pdp.commerceCard.promotion.promotions']}}
{{$productOrderCtrl.translations['antibody.pdp.commerceCard.promotion.viewpromo']}}
{{$productOrderCtrl.translations['antibody.pdp.commerceCard.promotion.promocode']}}: {{promo.promoCode}} {{promo.promoTitle}} {{promo.promoDescription}}. {{$productOrderCtrl.translations['antibody.pdp.commerceCard.promotion.learnmore']}}

Please note: We are reviewing Western blot images included in the antibody testing data in our catalog, including those provided by third parties. Unless expressly labeled or annotated as “raw-unedited”, Western blot images included in the antibody testing data in our catalog may have been edited, optimized or otherwise adjusted for presentation.
产品信息
PA5-111330
种属反应
宿主/亚型
分类
类型
抗原
偶联物
形式
浓度
规格
纯化类型
保存液
内含物
保存条件
运输条件
RRID
产品详细信息
Immunogen sequence: LIWRKHSASA LVLHGHNQNC DCSPDITLKI QFLRLLQSFS DHHENKYLLL NNQELNELSA ISLKANIPEV EAVLNTDRSL VCDGK
Highest antigen sequence indentity to the following orthologs: Rat - 100%, Mouse - 100%.
靶标信息
Substrate-specific adapter of a DCX (DDB1-CUL4-X-box) E3 ubiquitin-protein ligase complex required for cell cycle control. The DCX(TRUSS) complex specifically mediates the polyubiquitination and subsequent degradation of MYC. Also participates in the activation of NFKB1 in response to ligation of TNFRSF1A, possibly by linking TNFRSF1A to the IKK signalosome. Involved in JNK activation via its interaction with TRAF2. Also involved in elevation of endoplasmic reticulum Ca(2+) storage reduction in response to CHRM1.
仅用于科研。不用于诊断过程。未经明确授权不得转售。
篇参考文献 (0)
生物信息学
蛋白别名: Protein TAP1; Protein TRUSS; Short transient receptor potential channel 4-associated protein; TAP1 protein; TNF-receptor; TNF-receptor ubiquitous scaffolding/signaling protein; TP4AP; Trp4-associated protein
基因别名: C20orf188; TRPC4AP; TRRP4AP
Entrez Gene ID: (Human) 26133